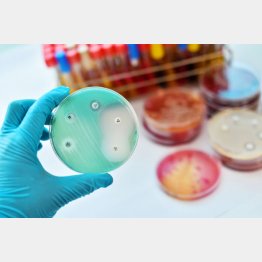

意外なところから発見され生まれたクスリがいくつもある
今回はちょっと番外編に近い内容になりますが、思いもよらぬところから発見されたクスリのエピソードを紹介します。高齢の方はもしかしたらご存じの話かもしれませんし、そういったクスリを現在進行形で使っているという方もいらっしゃるかもしれません。興味深い話だと思いますので、気楽に読んでいただけるとうれしいです。
こういった話をするときに真っ先に思い浮かぶのが、抗菌薬の「ペニシリン」です。ペニシリンの発見は、まさに偶然と言えるものでした。1928年、ある細菌学者が実験でブドウ球菌という細菌を培養しようとしたところ、その培地にアオカビが混入してしまいました。その結果、ブドウ球菌とともにアオカビも増殖したのですが、どういうわけかアオカビの周りにだけブドウ球菌が増殖していなかったのです。
細菌学者は「これはアオカビからブドウ球菌を増殖させない物質が出ているのではないか?」と考え、アオカビからの抽出物にも同様の作用があることを発見しました。そして、アオカビの学名である「Penicillium」から「ペニシリン」と名付けました。現在は他の抗菌薬もたくさん使われていますが、ペニシリンの発見は現在の抗菌薬治療の礎となっており、重要なものであったと言えます。